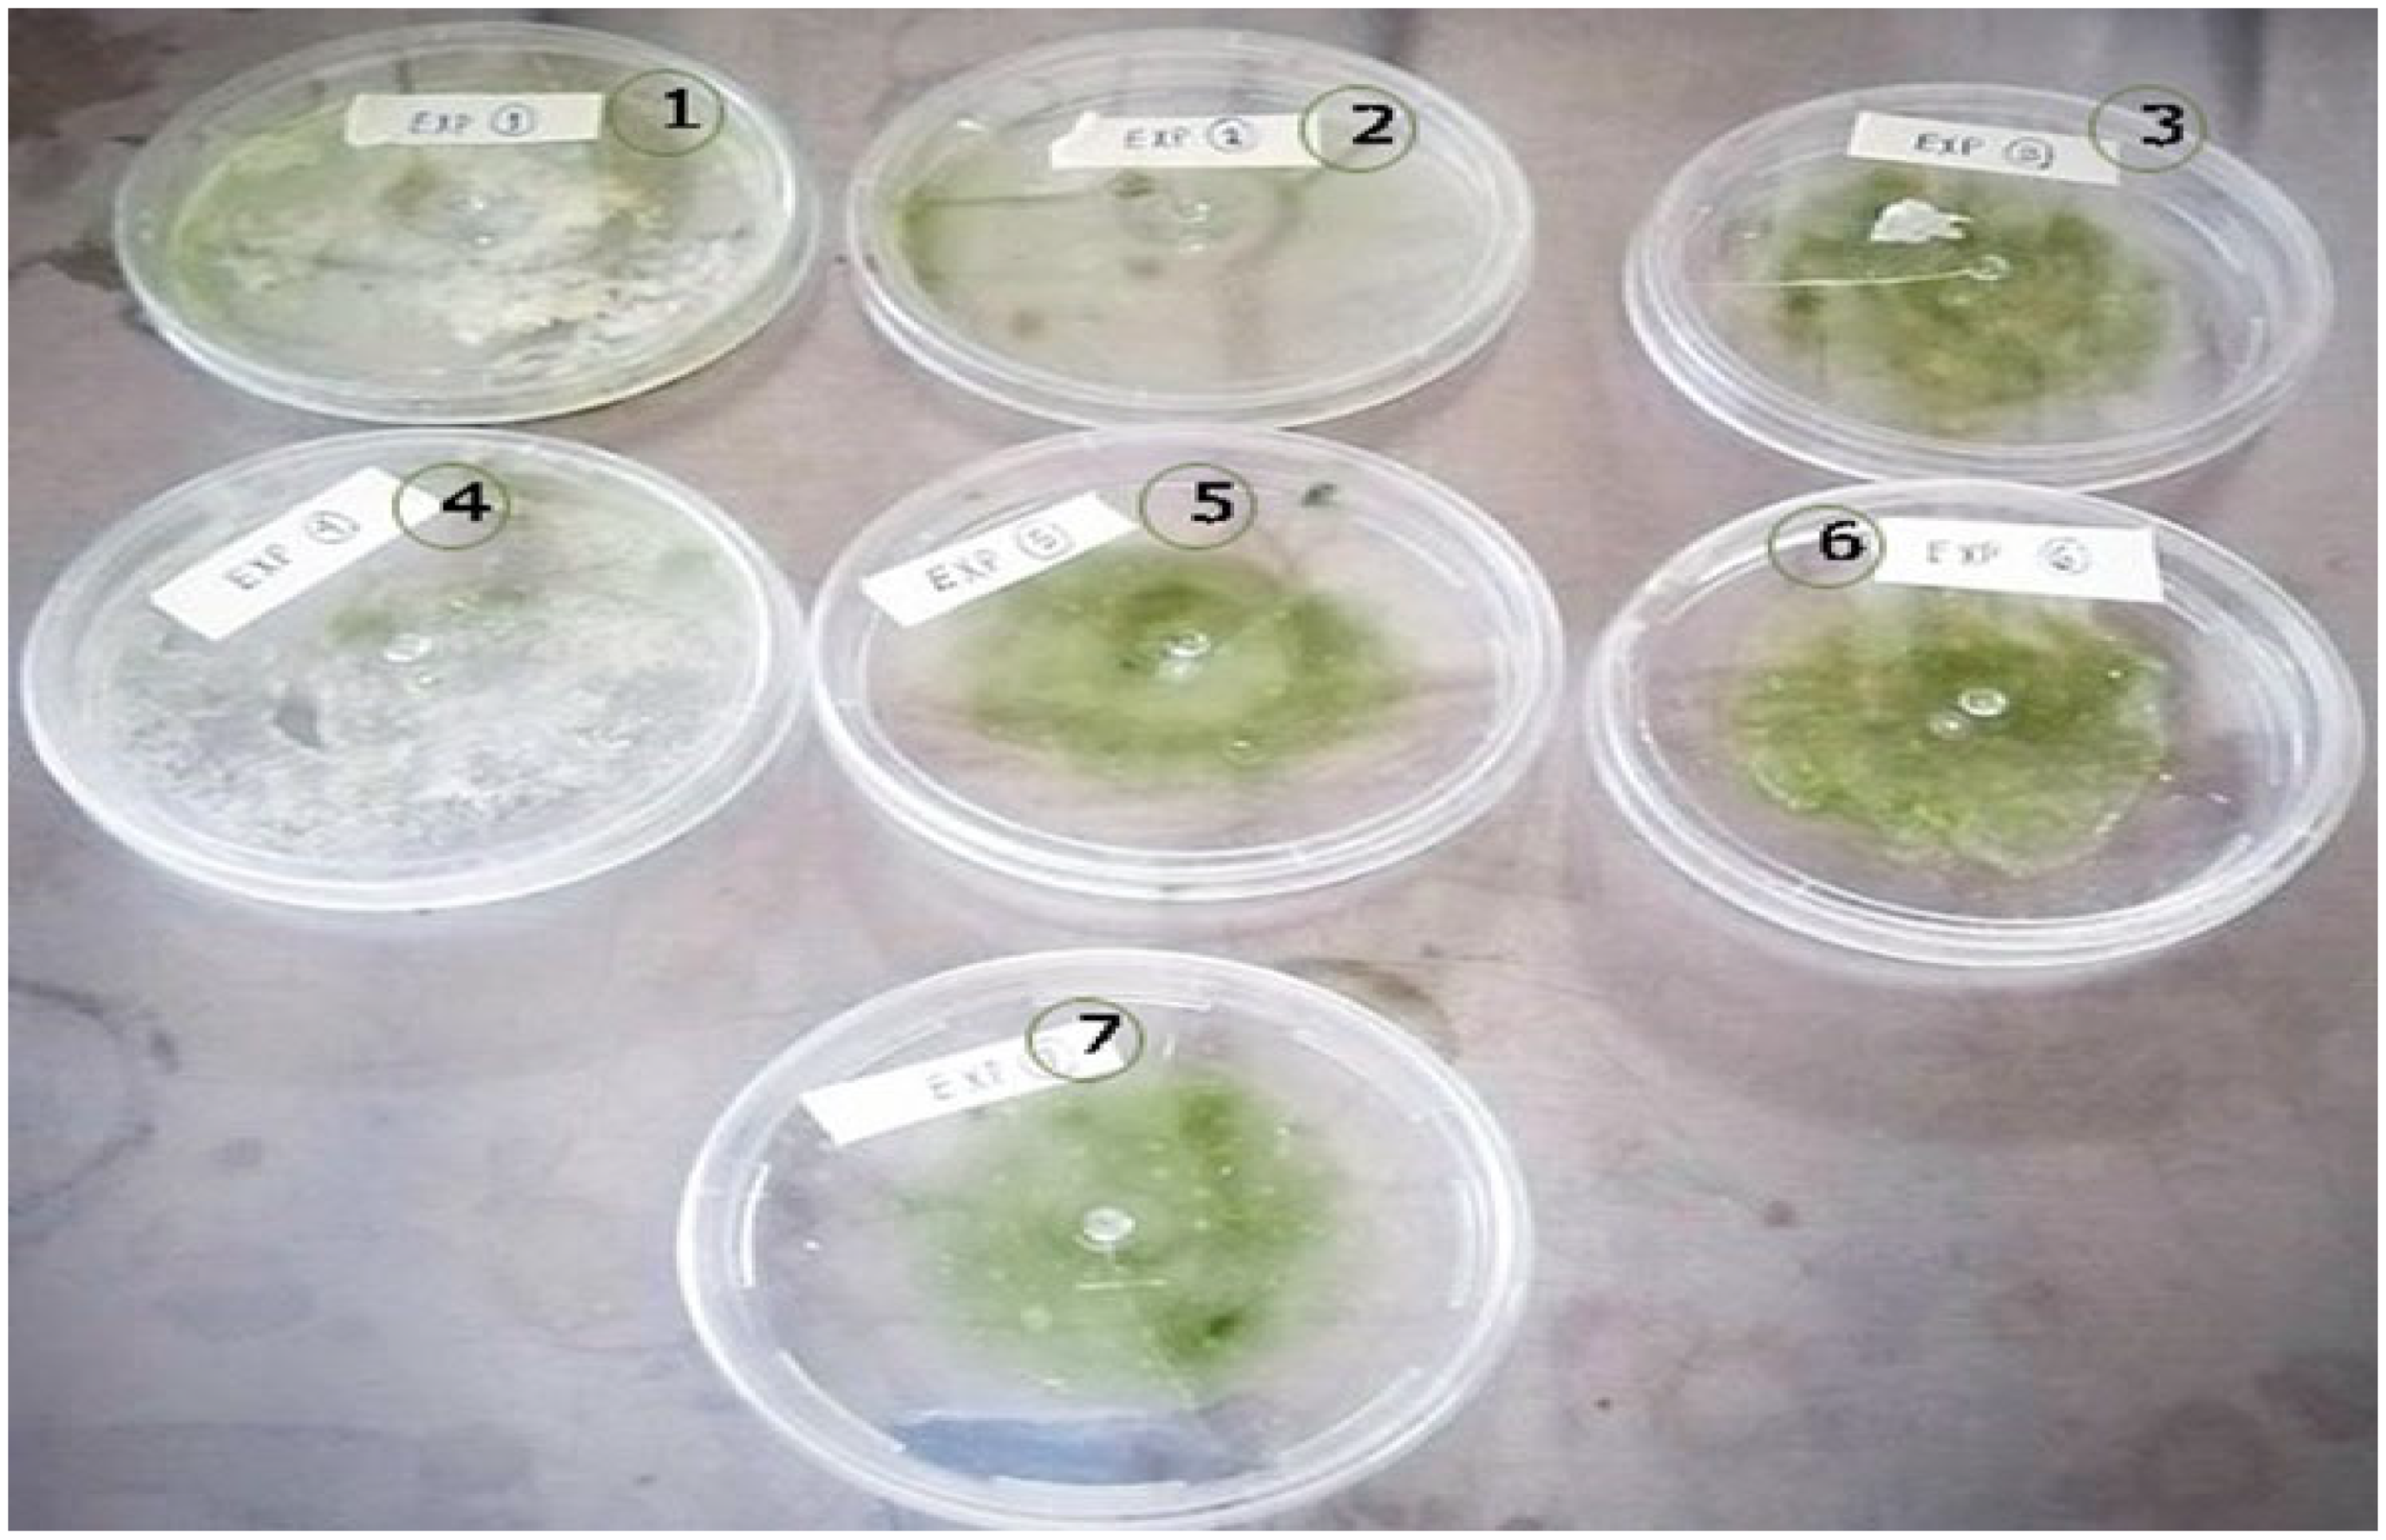
Polymers 15 02112 g007 Polymers 15 02112 g007

Preparation of Surgical Thread from a Bioplastic Based on Nopal Mucilage
Abstract
1. Introduction
2. Materials and Methods
2.1. Reagents and Nopal Harvest
2.2. Nopal Mucilage (NM) Extraction
2.3. Starch Extraction from Corn Grains
2.4. Bioplastics (BPs) Elaboration
2.5. Surgical Thread (ST) Preparation
2.6. Characterization of Nopal Mucilage and Bioplastic Additives
3. Results and Discussion
3.1. Nopal Mucilage (NM) Extraction
3.2. Characterization of the NM and Starch
3.3. Manufacture of the Bioplastics (BPs)
3.4. Analysis of Solubility in Solvents
3.5. Mechanical Properties of Bioplastics
3.6. Preparation of BP with Starch from Different Sources
3.7. Preparation of Surgical Thread with Different Plasticizers
4. Conclusions
Author Contributions
Funding
Institutional Review Board Statement
Data Availability Statement
Acknowledgments
Conflicts of Interest
Sample Availability
References
- Dassanayake, R.S.; Acharya, S.; Abidi, N. Biopolymer-based materials from polysaccharides: Properties, processing, characterization and sorption applications. In Advanced Sorption Process Applications; Edebali, E., Ed.; IntechOpen: England, UK, 2019; pp. 1–25. [Google Scholar] [CrossRef]
- Ferreira-Filipe, D.A.; Paço, A.; Duarte, A.C.; Rocha-Santos, T.; Patrício Silva, A.L. Are Biobased Plastics Green Alternatives?—A Critical Review. Int. J. Environ. Res. Public Health 2021, 18, 7729. [Google Scholar] [CrossRef] [PubMed]
- Tajirian, A.; Goldberg, D. A Review of sutures and other skin closure materials. J. Cosmet. Laser Ther. 2010, 12, 296–302. [Google Scholar] [CrossRef] [PubMed]
- Nawab, A.; Alam, F.; Hasnain, A. Biodegradable film from mango kernel starch: Effect of plasticizers on the physical, barrier, and mechanical properties. Starch 2016, 68, 919–928. [Google Scholar] [CrossRef]
- Baranwal, J.; Barse, B.; Fais, A.; Delogu, G.L.; Kumar, A. Biopolymer: A Sustainable Material for Food and Medical Applications. Polymers 2022, 14, 983. [Google Scholar] [CrossRef] [PubMed]
- Marques, A.P.; Reis, R.L.; Hunt, J.A. The biocompatibility of novel starch-based polymers and composites: In vitro studies. Biomaterials 2002, 23, 1471–1478. [Google Scholar] [CrossRef]
- Olmo, N.; Martin, A.I.; Salinas, A.J.; Turnay, J.; Vallet-Regi, M.; Lizarbe, M.A. Bioactive sol-gel glasses with and without a hydroxycarbonate apatite layer as substrates for osteoblast cell adhesion and proliferation. Biomaterials 2003, 24, 3383–3393. [Google Scholar] [CrossRef]
- Rossi, M.; Taboada-Liceaga, H.A.; Garcia-Mazcorro, J.F.; Gill, S.; Amieva-Balmori, M.; Hernández-Ramírez, G.A.; Whelan, K.; Remes-Troche, J.M. Fibre from nopal cactus (Opuntia ficus-indica) improves symptoms in irritable bowel syndrome in the short term: A pilot randomised-controlled trial. Proc. Nutr. Soc. 2020, 79, E13. [Google Scholar] [CrossRef]
- Lee, C.H.; Singla, A.; Lee, Y. Biomedical applications of collagen. Int. J. Pharm. 2001, 221, 1–22. [Google Scholar] [CrossRef]
- Farahnaky, A.; Saberi, B.; Majzoo, M. Bieffect of glycerol on physical and mechanical properties of wheat starch edible films. J. Text. Stud. 2013, 44, 176–186. [Google Scholar] [CrossRef]
- Luangapai, F.; Peanparkdee, M.; Iwamoto, S. Biopolymer films for food industries: Properties, applications, and future aspects based on chitosan. Rev. Agric. Sci. 2019, 7, 59–67. [Google Scholar] [CrossRef]
- Yadav, P.; Yadav, H.; Shah, V.G.; Shah, G.; Dhaka, G. Biomedical biopolymers, their origin and evolution in biomedical sciences: A systematic review. J. Clin. Diag. Res. 2015, 9, ZE21–ZE25. [Google Scholar] [CrossRef]
- Habig McHugh, T.; Krochta, J.M. Sorbitol- vs Glycerol-Plasticized Whey Protein Edible Films: Integrated Oxygen Permeability and Tensile Property Evaluation. J. Agric. Food Chem. 1994, 42, 841–845. [Google Scholar] [CrossRef]
- Delgado Hernández, J.L.A.; Jaquelina González Castañeda, J. El nopal de verdura en Guanajuato. Caso cooperativa pronopval scl. Valtierrilla, Salamanca, Gto. Rev. Mex. Agronegoc. 2005, IX, 450–462. [Google Scholar]
- Espino-Díaz, M.; Ornelas-Paz, J.; Martínez-Téllez, M.; Santillán, C.; Barbosa-Cánovas, G.; Zamudio-Flores, P.B.; Olivas, G.I. Development and Characterization of Edible Films Based on Mucilage of Opuntia ficus-indica (L.). J. Food Sci. 2010, 75, 347–352. [Google Scholar] [CrossRef]
- Pires, C.; Ramos, C.; Teixeira, G.; Batista, I.; Mendes, R.; Nunes, L.; Marques, A. Characterization of biodegradable films prepared with hake proteins and thyme oil. J. Food Eng. 2011, 105, 422–428. [Google Scholar] [CrossRef]
- Sepúlveda, E.; Sáenz, C.; Aliaga, E.; Aceituno, C. Extraction and characterization of mucilage in Opuntia spp. J. Arid Environ. 2007, 68, 534–545. [Google Scholar] [CrossRef]
- Rivera-Cañón, A.F.; Hernández-Carrillo, C.G.; Gómez-Cuaspud, J.A. Evaluation of physicochemical properties of Nopal (Opuntia ficus-Indica) as bio coagulant-flocculant for water treatment. IOP J. Phys. Conf. Ser. 2021, 2046, 012057. [Google Scholar] [CrossRef]
- Hernández-Carrillo, C.G.; Gómez-Cuaspud, J.A.; Martínez-Suarez, C.E. Compositional, thermal and microstructural characterizatiof the Nopal (Opuntia ficus indica), for addition in commercial cement mixtures. IOP J. Phys. Conf. Ser. 2017, 935, 012045. [Google Scholar] [CrossRef]
- Pascoe-Ortiz, S. Mezcla y Proceso, Para Elaborar un Material Plástico Biodegradable. IMPI Patente WO 2016/093685, 16 June 2016. [Google Scholar]
- Velasco-Aquino, A.A.; Espuna-Mujica, J.A.; Perez-Sanchez, J.F.; Zuñiga-Leal, C.; Palacio-Perez, A.; Suarez-Dominguez, E.J. Compressed earth block reinforced with coconut fibers and stabilized with aloe vera and lime. J. Eng. Des. Technol. 2021, 19, 795–807. [Google Scholar] [CrossRef]
- Amari, A.; Alalwan, B.; Eldirderi, M.M.; Mnif, W.; Rebah, F.B. Cactus material-based adsorbents for the removal of heavy metals and dyes: A review. Mater. Res. Express 2020, 7, 012002. [Google Scholar] [CrossRef]
- Aquilina, A.; Borg, R.P.; Buhagiar, J. The application of Natural Organic Additives in Concrete: Opuntia ficus-indica. IOP Conf. Ser. Mater. Sci. Eng. 2018, 442, 012016. [Google Scholar] [CrossRef]
- Casarrubias-Castillo, M.G.; Méndez-Montealvo, G.; Rodriguez-Ambriz, S.L.; Sánchez-Rivera, M.M.; Bello-Pérez, L.A. Structural and Rheological differences between fruit and cereal starches. Agrociencias 2012, 46, 455–466. [Google Scholar]
- Del Valle, V.; Hernández, P.; Guarda, A.; Galotto, M. Development of a cactusmucilage edible coating (Opuntia ficus indica) and its application to extend strawberry (Fragaria ananassa) shelf-life. Food Chem. 2005, 91, 751–756. [Google Scholar] [CrossRef]
- León-Martínez, F.M.; Rodríguez-Ramírez, J.; Medina-Torres, L.L.; Méndez Lagunas, L.L.; Bernad-Bernad, M.J. Effects of drying conditions on the rheological properties of reconstituted mucilage solutions (Opuntia ficus-indica). Carbohydr. Polym. 2011, 84, 439–445. [Google Scholar] [CrossRef]
- Salinas-Salazar, V.M.; Trejo-Márquez, M.A.; Lira-Vargas, A. Propiedades físicas, mecánicas y de barrera de películas comestibles a base de mucílago de Nopal como alternativa para la aplicación en frutos. Rev. Iberoam. Tecnol. Postcosecha 2015, 16, 193–198. [Google Scholar]
- Ballesteros-Mártinez, L.; Pérez-Cervera, C.; Andrade-Pizarro, R. Effect of glycerol and sorbitol concentrations on mechanical, optical, and barrier properties of sweet potato starch film. NFS J. 2020, 20, 1–9. [Google Scholar] [CrossRef]
- Vargas, L.; Figueroa, G.A.; Méndez, C.H.H.; Nieto, A.P.; Vieyra, M.I.G.; Núñez, J.R.R. Propiedades físicas del mucílago de nopal. Acta Univ. 2016, 26, 8–11. [Google Scholar] [CrossRef]
- Naod, G.; Tsige, G.M. Comparative physico-chemical characterization of the mucilages of the two cactus pears (Opuntia spp.) obtained from Mekelled northern, Ethiopia. J. Biomater. Nanobiotechnol. 2012, 3, 79–86. [Google Scholar] [CrossRef]
- Joaquín-Medina, E.; Patiño-Saldivar, L.; Ardilas, A.A.A.; Salazar-Hernández, M.; Hernández, J.A. Bioadsorption of methyl orange and methylene blue contained in water using as bioadsorbent natural brushite (nDCPD). Tecnol. Cienc. Agua 2021, 12, 304–357. [Google Scholar] [CrossRef]
- Abdullah, A.H.D.; Chalimah, S.; Primadona, I.; Hanantyo, M.G.H. Physical and chemical properties of corn, cassava, and potato starchs. IOP Conf. Ser. Earth Environ. Sci. 2018, 160, 012003. [Google Scholar] [CrossRef]
- Rodríguez-Pineda, L.M.; Muñoz-Prieto, E.J.; Rius-Alonso, C.A.; Palacios-Alquisira, J. Preparation and Characterization of Potato Starch Microparticles with Acrylamide by Microwave Radiation. Cienc. Desarro. 2018, 9, 149–159. [Google Scholar] [CrossRef]
- Jane, J.; Chen, Y.Y.; Lee, L.F.; McPherson, A.E.; Wong, K.S.; Radosavljevic, M.; Kasemsuwan, T. Effects of Amylopectin Branch Chain Length and Amylose Content on the Gelatinization and Pasting Properties of Starch. Cereal Chem. 1999, 76, 629–637. [Google Scholar] [CrossRef]
- Dong, S.; Fang, G.; Luo, Z.; Gao, Q. Effect of granule size on the structure and digestibility of jackfruit seed starch. Food Hydrocoll. 2021, 120, 106964. [Google Scholar] [CrossRef]
- Hernando-Pardo, O.C.; Castañeda, J.C.; Ortiz, C.A. Caracterización estructural y térmica de almidones provenientes de diferentes variedades de papa. Acta Agronómi. 2013, 62, 289–295. [Google Scholar]
- Agama-Acevedo, E.; Ottenhof, M.-A.; Farhat, I.A.; Paredes-López, O.; Ortíz-Cereceres, J.; Bello-Pérez, L.A. Isolation and characterization of starch from pigmented maizes. Agrociencia 2005, 39, 419–429. [Google Scholar]
- Lourdin, D.; Della Valle, G.; Colonna, P. Influence of amylase content on starch films and foams. Carbohydr. Polym. 1995, 27, 261–270. [Google Scholar] [CrossRef]
- Mali, S.; Sakanaka, L.S.; Yamashita, F.; Grossmann, M.V.E. Water sorption and mechanical properties of cassava starch films and their relation to plasticizing effect. Carbohydr. Polym. 2005, 60, 283–289. [Google Scholar] [CrossRef]
- Bastioli, C. Starch-polymer composites. In Degradable Polymers; Scott, G., Ed.; Springer: Dordrecht, The Netherlands, 2002. [Google Scholar] [CrossRef]
- Vieira, M.G.A.; da Silva, M.A.; dos Santos, L.O.; Beppu, M.M. Natural-based plasticizers and biopolymer films: A review. Eur. Polym. J. 2011, 47, 254–263. [Google Scholar] [CrossRef]
- Gacen, J.; Cayuela, D. Solubilidad diferencial de las fibras químicas de celulosa. Rev. Química Ind. Téxt. 2010, 199, 8–12. [Google Scholar]
- Navia-Porras, D.P.; Bejarano-Arana, N. Evaluation of physical properties of thermopressing bioplastics made from cassava flour. Biotecnol. Sect. Agropecu. Agroind. 2014, 12, 40–48. [Google Scholar]
- González, J.; Partal, P.; García, M.; Gallegos, C. Effect of processing on the viscoelastic, tensile and optical properties of albumen/starch-based bioplastics. Carbohydr. Polym. 2011, 84, 308–315. [Google Scholar] [CrossRef]
- Luo, X.; Li, J.; Lin, X. Effect of gelatinization and additives on morphology and thermal behavior of corn starch/PVA blend films. Carbohydr. Polym. 2012, 90, 1595–1600. [Google Scholar] [CrossRef] [PubMed]
- Smeak, D.D. Chapter 1: Selection and use of currently available suture materials and needles. In Current Techniques in Small Animal Surgery, 5th ed.; Bojrab, M.J., Ed.; Teton NewMedia: Philadelphia, PA, USA, 2014; pp. 1–11. [Google Scholar]
- Chu, C.C. Chapter 19: Textile-based biomaterials for surgical applications. In Polymeric Biomaterials, 2nd ed.; Dumitriu, S., Ed.; CRC Press: New York, NY, USA, 2001; pp. 1–54. [Google Scholar]

| Experiment | Mucilage (mg) | H2O (mL) |
|---|---|---|
| 1 | 1.05 | 10 |
| 2 | 1.03 | 20 |
| 3 | 1.04 | 30 |
| 4 | 1.01 | 5 |
| 5 | 1.02 | 15 |
| 6 | 1.53 | 30 |
| 7 | 1.51 | 10 |
| Starch | Sorbitol (mg) | Cellulose (mg) |
|---|---|---|
| Corn (CS) | 10 | 10 |
| 50 | ||
| 100 | ||
| 20 | 10 | |
| 20 | ||
| 50 | ||
| 100 | ||
| 30 | 10 | |
| 20 | ||
| 50 | ||
| 100 | ||
| Potato of Sigma Aldrich (SAPS) | 10 | 10 |
| 50 | ||
| 100 | ||
| 20 | 10 | |
| 20 | ||
| 50 | ||
| 100 | ||
| 30 | 10 | |
| 20 | ||
| 50 | ||
| 100 | ||
| Potato of Baker Analyzed (BAPS) | 10 | 10 |
| 50 | ||
| 100 | ||
| 20 | 10 | |
| 20 | ||
| 50 | ||
| 100 | ||
| 30 | 10 | |
| 20 | ||
| 50 | ||
| 100 |
| Solvent | Solubility | |
|---|---|---|
| B1 | B2 | |
| (A) Distilled water | Completely soluble | Completely soluble |
| (B) Ethyl alcohol | Insoluble | Insoluble |
| (C) Acetone | Slightly soluble | Slightly soluble |
| (D) Hydrochloric acid (0.1 M) | Completely soluble | Slightly soluble |
| (E) Acetic acid (0.1 M) | Highly soluble | Highly soluble |
| Bioplastic | Initial Weight (g) | Initial Dry Weight (Wds; g) | Final Dry Weight (Wdf; g) | Solubility (%) |
|---|---|---|---|---|
| B1 | 0.367 | 0.347 | 0.110 | 68.30 |
| B2 | 0.253 | 0.170 | 0.118 | 30.59 |
| Bioplastic | σF, MPa | EF, MPa | σT, MPa | ET, MPa |
|---|---|---|---|---|
| B1 | 2.71 | 278.4 | 1.87 | 340.1 |
| B2 | 4.12 | 333.2 | 3.97 | 373.2 |
Disclaimer/Publisher’s Note: The statements, opinions and data contained in all publications are solely those of the individual author(s) and contributor(s) and not of MDPI and/or the editor(s). MDPI and/or the editor(s) disclaim responsibility for any injury to people or property resulting from any ideas, methods, instructions or products referred to in the content. |
© 2023 by the authors. Licensee MDPI, Basel, Switzerland. This article is an open access article distributed under the terms and conditions of the Creative Commons Attribution (CC BY) license (https://creativecommons.org/licenses/by/4.0/).
Share and Cite
Herrera-Ibarra, E.; Salazar-Hernández, M.; Talavera-López, A.; Solis-Marcial, O.J.; Hernandez-Soto, R.; Ruelas-Leyva, J.P.; Hernández, J.A. Preparation of Surgical Thread from a Bioplastic Based on Nopal Mucilage. Polymers 2023, 15, 2112. https://doi.org/10.3390/polym15092112
Herrera-Ibarra E, Salazar-Hernández M, Talavera-López A, Solis-Marcial OJ, Hernandez-Soto R, Ruelas-Leyva JP, Hernández JA. Preparation of Surgical Thread from a Bioplastic Based on Nopal Mucilage. Polymers. 2023; 15(9):2112. https://doi.org/10.3390/polym15092112
Chicago/Turabian StyleHerrera-Ibarra, Evelyn, Mercedes Salazar-Hernández, Alfonso Talavera-López, O. J. Solis-Marcial, Rosa Hernandez-Soto, Jose P. Ruelas-Leyva, and José A. Hernández. 2023. "Preparation of Surgical Thread from a Bioplastic Based on Nopal Mucilage" Polymers 15, no. 9: 2112. https://doi.org/10.3390/polym15092112
APA StyleHerrera-Ibarra, E., Salazar-Hernández, M., Talavera-López, A., Solis-Marcial, O. J., Hernandez-Soto, R., Ruelas-Leyva, J. P., & Hernández, J. A. (2023). Preparation of Surgical Thread from a Bioplastic Based on Nopal Mucilage. Polymers, 15(9), 2112. https://doi.org/10.3390/polym15092112

